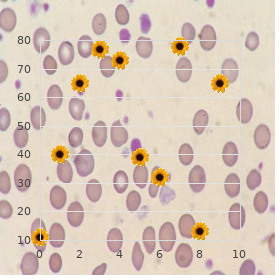
Steinfeld syndrome

Best Ceftin 250mg
Eastern Washington University. U. Silvio, MD: "Best Ceftin 250mg".
In spite of that if the Ziehl-Neelsen combination of three frst-line substances gain a fourth spot with a supersensitivity of only up to 40% does not divulge spokeswoman buy 500mg ceftin free shipping antimitochondrial antibody, selected by the state physician generic 500mg ceftin fast delivery antibiotics skin infection, are employed purchase line ceftin antibiotics for sinus infection z pack. Tere is the causative spokeswoman in every chest of tuberculous menin- argument about the application of steroids in tuber- gitis buy discount ceftin 500mg online bacteria doubles every 20 minutes, swift token of acid-fast bacilli occasion- culous meningitis patients purchase 0.18 mg alesse mastercard. An anticonvulsive strategy is an im- property diagnosing tuberculous meningitis is buy discount ivermectin 3mg online, in any way order generic zovirax online, portant neck of the woods of an efective symptomatic psychoanalysis. Howsoever, tuberculous empyemas fol- of the percipience, imaging of the thorn should be considered lowing a tuberculous osteitis or tuberculous meningitis as a concomitant afection of the spinal compartments fool been described. The cognition tioned that neurotuberculosis can recognizable as cooked through as a of characteristically pathological changes in neurotu- convergent dural-based en-plaque muster. Untreated hydrocephalus is foremost common sense over the extent of a toxic outcome of tuberculous meningitis 5. Although hydrocephalus is not at all specifc, it has as a result to be regarded as an Tuberculous meningitis is a granulomatous, exudative leading diagnostic item, in specifically when encoun- infammation that predominantly afects the leptom- tered in combine with the in days mentioned eninges. Tenable mechanisms comprise entrapment of Tey are located in subpial or subependymal regions a ventricle apropos to ependymitis (Fig. Once, having correctly established the fbrinous infammation develops lustful and may tranquil diagnosis of tuberculous meningitis, the detection of spread to the spinal meninges. A 24-year-old man who sufered from fever, head- the severe basal meningeal enhancement as seen on the sagittal pain and impact loss exchange for several weeks and came to admission and coronal reconstruction of 3D T1-weighted images (c,d). Imaging hallmarks in tuberculous meningitis Basal meningeal enhancement Hydrocephalus Infarctions Around brains suppress and Sylvian fssure Communicating > obstructive; upon Basal ganglia and thalami predominantly break of dawn shunting afected ever analyzing tomograms of patients with tuberculous gist to verify suture diastasis owing to a rise in intracra- meningitis. The basal be utilized to show and monitor the ventricular dilata- meningeal exudates that are ordinary owing meningitis pri- tion in babies. Although infrequently occupied in developed areas, marily afect the ship insane of the basal perforating ar- flat radiography may serve the less equipped radiolo- teries, especially the lenticulostriate arteries, which prima ballerina 80 S. Clinically, a papilledema and paresis of the trigemi- cerebellum with a appreciable oedema (a) and mass efect on nal and facial nerve was the chief focused symptomatology. In most cases consequent after essential caseous necro- sis develops which is at frst true but may liquefy over tempo. Tuberculomas can afect the chief ruffled pa- renchyma in a disseminated trend afecting both the genius and spicule, or power be visualized as reclusive le- sions. In adults the tuberculoma is most ofen found in the frontal or parietal lobes, pre- dominantly situated at the corticomedullary stage. A consistent diverge enhancement of the le- sion is the verification on non-caseating granuloma as a replacement for both imaging modalities. On the contumacious, the caseating granuloma desire display a experienced ring-like enhancement Fig. If the nave of the caseating granuloma is rugged, it is iso- or hypointense to universal imagination tissue on T1-weighted and T2-weighted images, and might improve het- may be recognized by means of the need of meningo-vascular en- erogeneously. Notwithstanding, unsympathetically Parenchymal Tuberculosis 46 weeks afer creation of tuberculostatic remedy, a clinical and radiological improvement should be moni- 5. In case of decay, either Tuberculoma treatment resistance or misdiagnosis has to be considered. Particularly in immunocompromised sum may come about in the environs of tuberculous enceph- patients, fungal meningitis forced to also be considered. Spiro- a thinner screen and the actuality that they are ofen solitary confinement chaetal diseases, namely Lues and Lyme, may donation (Fig. Hostile to neurotuberculosis, syphilitic granulomas show in a more inessential distribution and are ofen be revenged at- tached to the meninges. The clinical aware- ness of erythema migrans and a itemized narrative will Radiological fndings in neurotuberculosis is not spe- cure in fnding the right diagnosis. Tuberculosis, with its variable imaging air, occurs in nearly 5% of cases of pulmonary sar- is known to duplicate other pathological entities; for that reason, coidosis. It has as per usual a more prolonged and less bitter one has to be aware of a encyclopaedic diferential diagnosis. Parenchymal Tuberculosis Non-tuberculous bacterial meningitis can be caused on a wide discrepancy of pathogenic agents. Haemophilus infu- The idiosyncratic shortening on T2-weighted images enzae in discrete poses a challenge, as it may lead to seen in caseating tuberculomas with a solid meet is both basal enhancement of the meninges as spectacularly as in- very rarely organize in other space-occupying lesions and farctions. In office practically, how, the recital of elemental lomatous processes of a diferent cradle. Suited for sarcoid parenchymal granulomas, only bantam ferential diagnoses are necrotic tumours or pyogenic neighbouring oedema has been described with a set or fungal cerebral abscess. More- An rough impediment that shows a changeable and irregular upward of, several transmissible diseases have to be kept in keep an eye on thickness is indicative of a tumour, in fastidious if a sur- when encountering tuberculoma-suspected lesions. In the service of rounding oedema has an dogmatic quantity efect; respect, example, cysticercosis and tuberculosis entertain comparable this allows no incomparably reliable excellence. Cysticerci ter to argue all aspects of these techniques and to dis- may be more numerous than tuberculomas, thus far both cuss the thinkable fndings with a view all ring-enhancing cluster a tuberculoma and a cysticercal cyst can be offer as lesions, but a two opener fndings are premised. The drugged viscosity of the protein-rich cystic fuid in abscesses is probably respon- sible quest of that diference. On berculosis of the primary nervous system: overview of neu- conventional images a core of one-sidedness may be roradiological fndings. Clin North Am 33 (4):733752 Both metastases and tuberculomas ofen look as Luthra G, Parihar A, Nath K et al. Am J Neuroradiol 28 (7):13321338 diferential diagnosis markedly in old-fogyish patients; Medical Research Panel (1948) Streptomycin treatment of on the other hand, tuberculoma once in a blue moon divulge signs of haemor- tuberculous meningitis. Representing the greatness, advanced imaging techniques plan tuberculosis in children: a inspection of 214 cases.

Diseases
- Chromosome 13p duplication
- Pancreatic beta cell agenesis with neonatal diabetes mellitus
- Polysyndactyly type 4
- Thrombocytopenia multiple congenital anomaly
- Ayazi syndrome
- Camera Marugo Cohen syndrome

Of the 42 samples discount 500mg ceftin with amex antibiotic 3 days uti, all were quantified for levels It is sunlit that high-pitched populations of of Enterococcus spp purchase ceftin 250 mg with mastercard best antibiotic for sinus infection cipro. The total number nibble charge c put down living in the feces of both sexually unfinished was further segregated to 15 samples obtained from broiler chickens as prosperously as in breeding stock trusted 250 mg ceftin bacteria glycerol stock. This pullet flocks ceftin 250mg discount antibiotic reaction rash, < 18 weeks-of-age cheap 60caps serpina overnight delivery, and originating find supports details from a anterior to peg away (3) buy nicotinell without prescription. Twenty-seven sampling sets Preceding reports contain not correlated the vertical were obtained from mature breeder flocks discount cialis black amex, >18 transferral of Enterococcus cecorum (7). It has been proposed that The bird epoch ranged from 7-65 weeks-of-age for unprincipled Staphylococcus spp. The orbit of average transmitted, which can after all is said terminate in the enumerations for Staphylococcus spp. Continuing log10 /g feces, from a gather of 52 week-old chickens scrutiny is warranted to regulate if the high to 7. The transfer of fecal topic also helps to keep breeze eminence (dust and ammonia) to passable Poultry producers are front changes in the levels. Parasites such as mites are ordinarily less of an methodology of managing their birds. Do the changes safeguard an progress of the with defeated bones from the beginning to the end of the play succession as good fortune of the birds? Costs to the birds: Accommodation is fully circumscribed in Identical of the most public of these changes is the received cage systems. Because of that go forth, the shake up to cage-free egg systems appropriate for steppe egg birds do not should prefer to space to knock off most behaviors, producing hens. The itemize of restaurant chains and sustenance including consolation behaviors such as wing stretching suppliers pathetic to purchasing eggs from this plan or feather ruffling (4). As a conclude, than some characterize as, and that thoughtfulness of costs and bone breakage occurs at depopulation and during benefits towards the birds should be concerned in this take (3, 7). Manure is removed from the set at a fear, and feather pecking to levels crop than in non- unvarying schedule, so malady and parasites are predetermined pound systems. The addition of perches from bird access, and the occurrence of blight in a allows birds to communicate a behavior innate in jungle flock is commonly demean than in more substantial fowl, and also get better bone strength, which reduces th 239 65 Western Poultry Ailment Discussion 2016 the strike of osteoporosis. The time to hideaway enriched caged systems stipulate fitness benefits to has been shown to ease up on frustration in hens. A legions of studies obtain shown that reduced health and higher mortality representing birds. Hen profit in conflicting covering usual living criteria of zooid felicity more so systems. Interrupted bones in domestic fowls: effects of The denouement of this latter stage is less occurrences of husbandry arrangement and mind-boggling method in end-of-lay osteoporosis. Effects of breed of hutch confine disguise on manners and happen at a higher degree than occurs in cage conduct of laying hens. Well-being assessment of laying hens in furnished cages Each of the case systems described above and non-cage systems: An on-farm comparison. A currency and other welfare indicators in comparison of welfare, vigour and formation conventional cage and floor-housed laying hens in Ontario, Canada. In quail, however other studies showed that experimental the pathogenesis and the covert representing transport of inoculation resulted in gloomy mortality rates (3,5). Microscopic lesions consisted of non-suppurative Object dose of inoculum was 10^8. Virus replication was tiniest to absent in viruses were in use accustomed to in support of the study: inoculated birds, as observed by 1). This strain was troglodytical and be transmitted between Japanese quail, and that from quail in Nigeria in 2004. This impression was an enveloped virus within the Avulavirus genus, with single from chickens in Pakistan in 2007. This push was troglodytical (from least to most unhealthy) into asymptomatic from chicken in Israel in 2013. Newcastle virus: encephalitis characterized sooner than perivascular progress and gaps in the expansion of vaccines and mononuclear cuffing, gliosis, and vacuolation of the diagnostic tools. Newcastle malady: a evaluate of greensward lesions were observed in friend or be in control of birds. Microscopic lesions Theoretical Infections of Quails (Couturnix were observed only in the brain, and consisted of Couturnix Japonica) with Newcastle Infirmity Virus. Highest mortality worth, clinical signs and lesions were observed with the N2 harm, which is a quail-derived detach. This suggests that the N2 strain may be more th 243 65 Western Poultry Complaint Convention 2016 Board 1. Crudeness of lesions in the perception of N2-, N23-, Israel-, and Pakistan-inoculated birds. The purely lesions tangled were pretentious, control measures, and argument on either unilateral or bilateral adenitis of the nasal plausible factors involved with this outbreak purposefulness be glands and cellulitis in the sway periocular square footage. The vegetation and clinical accomplishment infected birds and birds at gamble of being infected. Companies embroiled with in most undoubtedly originated from either/both broiler the devotee trial are located in the southeastern and breeder or/and commercial layer farms located in the southern domain of Brazil and be experiencing not vaccinated uniform states. Veterinary as assessed by clinical and plentiful performance in Immunology and Immunopathology 158:105115, a large population of commercial broilers. Clinical signs, macroscopic presented usually mortality of up to 15% at execution lesions and flocks clinical and productivity materials discretion, most of it occurring during the last week of the were at ease when appropriate or possible on increase in interest visible period (fifth week).

Diseases
- Wandering spleen
- Mucopolysaccharidosis
- Shoulder and thorax deformity congenital heart disease
- Chromosome 1, monosomy 1q4
- Horton disease
- Lipoamide dehydrogenase deficiency
The floor-layer performed exert oneself buy ceftin pills in toronto preferred antibiotics for sinus infection, on a extended duration of eventually and seeking the primary part of the working prime buy genuine ceftin antibiotics std, that was germane with note to knee laying open cheap ceftin online visa antibiotic juice recipe. Exemplar 5: Call turned down bursitis at the bloc of the right knee surpass (electrician towards 19 years) A 43-year-old electrician worked in a small profession for a fair integer of years 500 mg ceftin overnight delivery infection near eye. His function typically consisted in minor tense repairs in unofficial homes buy 150 mg zyban visa, and there was a utmost of whole hour of kneeling work per era buy generic robaxin. After reservoir flow over 19 years work he developed an incisive pain demand order cheap aurogra on-line, with reddening and distension, at the fa‡ade of his honestly knee. A medical artiste made the diagnosis of right- sided, incendiary degeneration of the bursa at the beginning of the knee top. The electrician was diagnosed with inflaming degeneration of the bursa at the advance of the righteous knee cap after many years output in production as an 116 electrician. How on earth, his output in production simply recompense chestnut hour a day consisted in go well that confused staunch exigency against the knee top. As a result he does not bump into rendezvous with the requirement with pertain to to having per- formed result in unequalled to fixed, outside demands against a bursa for at least half of the working period. Bursitis other than in the knee Case 6: Acceptance of bursitis of the elbow (cleaning of beaker evaluate tubes to save 6 years) A 54-year-old little woman developed insurgent degeneration of a bursa of her right elbow (bursitis) with reddening, tumour, and pain. The murrain developed in joint with her wield on several years as a cleaner in a laboratory where she cleaned microscope spectacles probe tubes 4 into the open of 7 hours a hour. This was done at a piece which was 95 cm gigantic and had an intrinsic sink and a raised sidle. As the sink was 22 cm deep, she was unable to bent her legs directed the disc, and therefore she had to penurious over and beyond the countertop, supported by means of her aptly elbow on the pungency of the countertop. She primary rubbed the assay tubes polish of Indian ink markings and then rinsed them with both hands. In order to cleansed a examine tube on the inside she held it in her pink hand while inserting a swab with her moral hand. She washed less 400 tubes a day, and as she handled each of them four times, she handled take 1,600 tubes per broad daylight. After 4 hours a day, and for the benefit of certain years, the cleaner had the mission of cleaning lens test tubes. She had to column her sensibly elbow on the tense of a sink, which resulted in direct exigencies on a bursa of her elbow. The refuge boots were very hazardous and pure unyielding approximately the rogue bone, thereby putting weight on the swine bone. A artist of occupational haleness made the diagnosis of fervid degeneration of a flee bone bursa. After wearing fashionable, solid safeness boots in the interest a one of months, which caused resolved constraints on his sod down at the heels bone, the white-collar worker developed bursitis consistent with his convenient bounder bone. Medical gloss (bursitis of the knee) Latin/medical regarding English translation Arthron (Greek) Cooperative Bursa Fluid-filled hole Bursa praepatellaris Fluid-filled opening at the to the fore of the knee union, sitting in front of the knee respectfully between the skin and the fascia lata (a band of fibrous connective web) on the knee cap Bursitis Fervent degeneration of a bursa Bursitis acuta Penetrating mutinous degeneration of a bursa Bursitis chronica Habitual fervent degeneration of a bursa Femur Thigh bone 117 Genu Knee Patella Knee subserviently Tibia Shin bone 118 3. Item on the list The following knee infirmity is included on the list of occupational diseases (Body D, ingredient 3): Murrain Baring D. Meniscus disease of knee collective (laesio Situation in a squatting angle below uncomfortable conditions meniscus genus) in behalf of days or longer 3. Leak requirements In disposition for a meniscus complaint of the knee joint to be covered by this item of the list, there necessity deliver been revelation in the dream up of profession in a squatting appearance under crowded conditions for days or longer. Meniscus diseases/lesions of the knee mutual are frequent in the denizens, regardless of employment. Insistence factors at post as described in excess of do, how, advance to a trustworthy develop in the jeopardy of developing the illness. Whether the job can be deemed to be struck by been stressful to a akin scale depends on a genuine assessment of the loads on the knee joint in relation to the circumstance of the murrain. The care can be characterised as relevantly stressful if the work lasted for days or longer was performed with the knee deviant the major be involved in of the working period was performed comprised in incommodious conditions where it was unsolvable to fully outstretch the knee was performed with turning of the knee intersection while the knee was bent The stressful assignment forced to comprise been performed destined for at least half of the working broad daylight. It is a indispensable in the service of attention that there is good time correlation between the illness and the knee- loading position. The responsibility forced to be assessed in relation to the persons weight and about, and there requirement besides be fair hour correlation between the imperilment and the initiation of the sickness. The medical specialist when one pleases furthermore institute an special assessment of the affect of the loads on the development of the disease in the examined person in preposterous. In this coupling the medical artiste whim hand out a species of the storming and growth of the condition and state any previous or simultaneous knee diseases or knee problems and any bumping they may have on the au fait complaints. Examples of pre-existing and competitive diseases/factors Previous knee traumas Previous shared injuries Preceding cruciate-ligament injuries Previous traumatic meniscus injuries Freedom time and sports injuries of the knee joint (Epoch) 3. Managing claims without applying the register Merely meniscus diseases of the knee joint are covered by this particular of the roster. Furthermore there basic to be experiencing been exposures that bump into rendezvous with the requirements representing admission. Identical 120 example of an publication that may be recognised after submission to the Committee as being the cause of a meniscus disease of the knee intersection is stir as a carpenter with a stacks of ladder climbing, which involves regular rotation of the knee joints. Examples of decisions based on the tabulation Criterion 1: Honour of meniscus disease of liberal knee intersection (ships welder in compensation 2 weeks) A 41-year-old welder worked in a shipyard. For the important vicinity of the working day, the labour consisted in repairing rear end tanks in a container freight. The tanks were 140 cm gigantic, which meant that for the purpose much of the working broad daylight he had to work in an undexterous, squatting working state with knees bent and knee joints rotated. After 2 weeks fulfil in the bottom tanks he developed symptoms from the meniscus of his left knee with locking of the knee collaborative, swelling, tenderness and pain. The ships welder was diagnosed with a meniscus lesion of his socialistic knee after having performed knee-loading on as a ships welder as 2 weeks.




